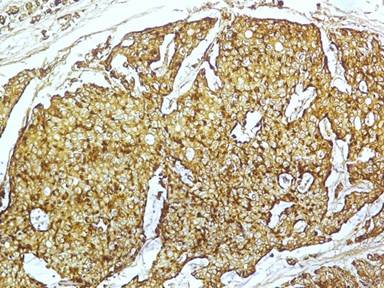

ORIGINAL ARTICLE
JOP. J Pancreas (Online) 2012 May 10; 13(3):263-267.
Neuroendocrine Tumors of the Ampulla of Vater: Presentation, Pathology and Prognosis
Mayank Jayant1, Rajpal Punia2, Robin Kaushik1, Rajeev Sharma1, Atul Sachdev3, Nikhil K Nadkarni3, Ashok Attri1
Departments of 1Surgery, 2Pathology and 3Medicine, Government Medical College and Hospital. Chandigarh, India
ABSTRACT
Context Neuroendocrine tumors of the pancreatic ampulla are uncommon. The final diagnosis is based on histology, and at times, it may be difficult to diagnose them pre-operatively since they present with a similar clinical picture to adenocarcinomas of this region. Objective To identify neuroendocrine tumors of the ampulla, as well as their presentation and management. Design A retrospective review of patients treated at a tertiary care institute was performed over a six-year period from 2005 to 2010. Patients Cases with periampullary cancers were investigated. Main outcome measures The case records were scrutinised for the clinical presentation, management and outcomes. Results A total of 4 cases (7.7%) of neuroendocrine tumors of the ampulla were identified from 52 patients with periampullary lesions, at a mean age of presentation of 49 years. The common mode of presentation was progressive jaundice (3 of 4 patients); pancreaticoduodenectomy was performed in 3 patients. One patient underwent palliative endoscopic stenting for metastatic disease. On histopathology, 2 of the patients had poorly differentiated (neuro)endocrine carcinoma (high grade), and 2 had well differentiated (neuro)endocrine carcinoma (1 low grade and 1 intermediate). All the tumors stained positively with chromogranin A. The patients who underwent pancreaticoduodenectomy are on regular follow-up and remain free of disease. Conclusions Neuroendocrine tumors of the ampulla are distinct entities presenting clinically with jaundice. They stain positive with chromogranin A on histopathology. Pancreaticoduodenectomy should be performed as it is associated with good outcome.
INTRODUCTION
A neuroendocrine tumor is defined as an epithelial neoplasm that shows neuroendocrine differentiation when analyzed by conventional histological, immunohistochemical, ultrastructural and biological evaluation [1]. Ampullary neuroendocrine tumor (ANET) are an extremely uncommon subset of pancreatic cancer that have a distinct clinical and morphological profile. ANET, formerly known as carcinoid tumors, account for only about 0.3 to 1% of all gastrointestinal neuroendocrine tumors, and even less than 2% of all periampullary cancers [2, 3]. To the best of our knowledge, a search of available English language literature revealed only about 139 patients with ANET that have previously been reported [1, 2, 3]. We report four cases of ANET with emphasis on their clinical presentation, pathology, treatment and outcomes.
MATERIAL AND METHODS
A retrospective review of the records of all the patients diagnosed as periampullary cancer at our hospital was performed, over a 6-year period, from January 2005 up to December 2010. A total of 52 patients were identified as having periampullary neoplasms, in whom the initial assessment was done with endoscopic retrograde cholangiopancreatography (ERCP) and final histopathological diagnosis was made from endoscopic biopsy or pancreaticoduodenectomy specimen. Of these, 48 (92.3%) were adenocarcinoma and 4 (7.7%) were neuroendocrine tumors.
Depending upon the stage of the disease at presentation, these periampullary cancers were either taken up for surgery (46 patients, 88.5%) or palliative endoscopic stenting (6 patients, 11.5%). Of the patients who were operated, 30 successfully underwent pancreaticoduodenectomy (65.2%) whereas 16 (34.8%) could only be palliated for their biliary/gastric obstruction.
The indoor records of the 4 patients of ANET were scrutinized for information regarding presentation, histopathology and management.
ETHICS
The informed consent was not taken as the study was retrospective review of the last 6 years, as well as the Declaration of Helsinki/IRB approval are not required in our institute for retrospective review studies.
STATISTICS
Descriptive statistics only were used (absolute and relative frequencies).
RESULTS
Neuroendocrine tumors accounted for 7.7% (4 out 52) of all tumors of ampulla. The details of these patients are tabulated in Table 1. Of these four patients, 2 were men and 2 were women. Although the mean age at presentation was 49 years (range 30-70 years), the female patients presented at a younger age as compared to the males. The common clinical presentation was with progressive jaundice (3 of 4 cases) and in the other, the presentation was with vague abdominal pain. One patient had associated neurofibromatosis. Endoscopic findings were similar in all the cases showing bulky ampulla with minimal mucosal ulceration. The diagnosis of ANET was made pretreatment only in one patient (Case #1). None of the patients had any symptoms/syndromes that could be attributed to hormonal hypersecretion by the ANET.
|
Table 1. Details of patient presentation. |
|||||||
|
Patient |
Age |
Sex |
Clinical presentation |
ERCP |
CECT/MRI |
Treatment |
Survival |
|
#1 |
62 |
Male |
Painless jaundice; lump lower abdomen |
Dilated CBD with submucosal bulge at ampulla |
Periampullary mass (3.5x2.5 cm); liver metastasis; mass in pelvis (11.7x13.0 cm) |
Biliary stenting |
Died |
|
#2 |
30 |
Female |
Painless jaundice |
Dilated CBD and bulky ulcerated ampulla |
Dilated CBD with soft tissue mass at ampulla (1.5x2.0 cm) |
Pancreaticoduodenectomy |
Alive |
|
#3 |
70 |
Male |
Pain upper abdomen |
Dilated CBD with prominent ampulla with normal mucosa |
Dilated CBD mass at ampullary region |
Pancreaticoduodenectomy |
Alive |
|
#4 |
35 |
Female |
Abdominal pain and jaundice |
Bulky ampulla with dilated CBD |
Periampullary mass (3x2 cm) |
Pancreaticoduodenectomy |
Alive |
CBD: common bile duct
Three patients underwent pancreaticoduodenectomy, but in the fourth, palliative biliary stenting had to be performed since the disease was metastatic. The tumor in resected specimens were in form of bulky ampulla (Figure 1) and measured 1.7-2.5 cm. One out of the two patients with metastatic disease died within a month of stenting, but the other three patients who were operated are doing well on follow-up.

|
Figure 1. Clinical photograph showing submucosal lesion in periampullary region (Case #3). |
Histological diagnosis of neuroendocrine tumors was made on basis of typical neuroendocrine morphology seen on hematoxylin-eosin staining (H&E, Figure 2). Immunohistochemical staining was further used for establishing the diagnosis of ANET in these tumors; a positive stain for chromogranin A was seen in all our patients (Figure 3). Two patients had poorly differentiated (high grade) (neuro)endocrine carcinoma and two had well differentiated (one low grade and one intermediate grade) (neuro)endocrine carcinoma as per the WHO classification system (Table 2).

|
Figure 2. Photomicrograph showing nests of uniform looking tumor cells in the submucosa (Case #4; H&E x100). |
|
Figure 3. Photomicrograph showing nest of tumor cells positive for chromogranin A (Case #4; x200). |
|
Table 2. Histopathological details of the patients. |
|||||||||
|
Patient |
Tumor size |
Histological feature |
Necrosis |
Extent of invasion |
Mitosis |
Metastasis |
Grade |
Immunostains with chromogranin A |
Final comment |
|
#1 |
3.5x2.5 |
Solid sheets |
Yes |
Could not be assesseda |
>20 per HPF |
Liver, pelvis |
High |
Positive |
Poorly differentiated (neuro)endocrine carcinoma |
|
#2 |
1.7x1.5x1.2 |
Nests and ribbons |
No |
Muscularis propria |
2 per 10 HPF |
- |
Low |
Positive |
Well differentiated (neuro)endocrine carcinoma |
|
#3 |
2.5x0.3 |
Nests and solid sheets |
Yes |
Muscularis propria |
22 per HPF |
- |
High |
Positive |
Poorly differentiated (neuro)endocrine carcinoma |
|
#4 |
2.0x1.2x0.6 |
Nests and sheets |
No |
Muscularis propria |
8 per HPF |
Lymph nodes |
Intermediate |
Positive |
Well differentiated (neuro)endocrine carcinoma |
a Endoscopic biopsy
DISCUSSION
ANET are extremely rare tumors, accounting for less then 1% of all gastrointestinal neuroendocrine tumors and less than 2% of all tumors of ampullary region [3, 4]. To the best of our knowledge, only 139 cases have been documented in available English language literature till date, and only about 20% of these reported patients are of African or Asian Pacific origin [3].
Earlier, all neuroendocrine tumors arising in the gastrointestinal tract were called carcinoid tumors, but today, this terminology has been abandoned, and they are preferentially called neuroendocrine tumors (however, the term carcinoid is still used for low grade tumors). Histologically, although ANET are similar to neuroendocrine tumors arising from other parts of gastrointestinal tract, they have distinct ultrastructural and immunohistochemical behavior. Immunohistochemical staining is the main diagnostic method for these tumors, and ANET stain positively with chromogranin A and synaptophysin in 92-100% cases [4, 5].
According to the International Classification of Diseases of Oncology, published by the World Health Organization (WHO), the ampulla has been designated a site specific code “241” and neuroendocrine tumors are given specific codes: neuroendocrine not otherwise specified (8246); small cell neuroendocrine carcinoma (8041); and large cell neuroendocrine carcinoma (8013) [5]. The earlier system of identifying these tumors on the basis of hormones secreted or the clinical syndrome produced is no longer recommended, since the majority of these are not functional, and the prognosis of such tumors is based on their histological grade.
Various systems of nomenclature, grading and staging neuroendocrine tumors are prevalent which cause much confusion. But the majority of nomenclature system including WHO, European Neuroendocrine Tumor Society (ENETS) and TNM reflect differentiation and grading features of neuroendocrine tumors [6]. Essentially, in all systems, these tumors are categorized as well or poorly differentiated on the basis of their proliferative rates assessed by amount of necrosis, mitotic figures/HPF or Ki67 labeling index [6, 7, 8].
ANET do not show any sex predilection, and are seen equally among males and females. The Surveillance, Epidemiology, and End Results (SEER) database reported 76 males and 63 females out of a total of 139 cases of ANET, with an average age of 61 years for carcinoids (low grade ANET) and 62 years for high grade neuroendocrine tumors [3]. Again, although we also had an equal incidence in males and females, the age of presentation was much younger in the female patients.
Owing to its location at the ampulla, ANET mostly present with obstructive jaundice (53%), non specific upper abdominal pain (24%), pancreatitis (6.0%) or weight loss (3.6%) [9, 10]. Jaundice was the common presentation in our patients also, and the other patient who presented with non specific abdominal pain without jaundice was diagnosed on ERCP that was performed for dilated extrahepatic biliary system seen on ultrasound examination. At times, the presence of neurofibromas in such patients may indicate the possibility of ANET, since neurofibromatosis type 1 has a well documented association with gastrointestinal tumors such as neurofibromas, gastrointestinal stromal tumors (GIST) and periampullary carcinoids, and these may be seen in up to 25% of patients with neurofibromatosis [11, 12]. In a recent review, 76 patients with neurofibromatosis type 1 were found to have periampullary or duodenal neoplasms. Of these, 31% were found to arise from the ampulla, and somatostatinoma (40%) was the commonest tumor type [12]. Less than 3% patients with neuroendocrine tumor of ampulla have hormonal hypersecretion syndrome [13].
ERCP is commonly used to diagnose ampullary tumors as well as to obtain tissue for histopathology. ANET characteristically proliferate under an intact mucosa [14]. The finding of a submucosal bulge at the ampulla on endoscopic examination should raise the clinical suspicion of ANET; this is the reason that the rate of preoperative diagnosis on endoscopic biopsy is as low as 14% [4, 9]. Endoscopic ultrasound is helpful in detecting the depth of invasion and the presence of lymph node metastasis, but the facility may not be available at all the places. Computed tomogram scan and octreotide scan are helpful in a metastatic workup once the diagnosis of ANET is established [4, 15]. However, there are no specific features on imaging that can help in distinguishing ANET from the more common adenocarcinoma.
Tumor size has been regarded as a prognostic marker for adenocarcinoma of periampullary region. Singhal et al. in their comparison of adenocarcinoma and carcinoids of periampullary region observed that average size of carcinoid tumor was 5 cm and adenocarcinomas above 5 cm were seldom resectable [16]. However, tumor size does not predict the metastatic potential in ANET, and although a tumor size of more than 2 cm was found to be associated with lymph node metastasis, there are several reports of ANET up to 5 cm size without evidence of any metastasis [2, 17, 18].
Grossly neuroendocrine tumors of ampulla are small, solitary, polypoid and are covered with flattened mucosa. Microscopically the tumor is arranged in nests, microglandular, trabecular and rarely insular pattern. The tumor cells are small, uniform with scanty granular cytoplasm. The nuclei are regular, normochromic with scanty mitosis. Obvious evidences of malignant behavior are vascular invasion, gross local invasion or metastasis [3, 6].
The treatment protocol for ANET remains controversial, as they are rare tumors with an unpredictable biological behavior and prognosis [6]. Since tumor size has not been clearly established to correlate with lymph nodal positivity status, pancreaticoduodenectomy is often recommended as the treatment of choice for tumors of any size with no distant spread [10, 19, 20]. Although less invasive procedures like local excision and endoscopic resections have also been successfully attempted, especially for ANET less than 2 cm size or in high risk surgical candidates [13, 14, 21], extensive debulking surgery should be considered in patients with hormonal hypersecretion, even in the presence of advanced disease (extensive local or distant metastasis) since it offers survival rates of up to 80% at 5 years [6].
Tumor characteristics (grade) and distant metastasis are the most important prognostic factors in determining survival in ANET. Other tumor properties, like nodal involvement, tumor size and resection margins, appear to be of lesser significance in the long term survival [1, 22, 23, 24]. Low grade tumors show a 5- and 10-year survival rate to the tune of 80% and 71%, respectively, whereas high grade neuroendocrine tumors have dismal 5- and 10-year survival rates (15%) [3, 25].
Received October 29th, 2011 - Accepted March 12th 2012
Key words Ampulla of Vater; Neuroendocrine Tumors; Pancreaticoduodenectomy
Abbreviations ANET: ampullary neuroendocrine tumor
Financial disclosure None
Conflict of interest The authors have no potential conflict of interest
Correspondence
Mayank
Jayant
Department of Surgery
Government Medical College and Hospital
Sector 32, Chandigarh
160 030 India
Phone: +91-964.612.1564
Fax: +91-0172.260.8488
E-mail: mayankjayant@rediffmail.com
References
1. Selvakumar E, Rajendran S, Balachandar TG,Kannan DG,Jeswanth S, Ravicahndran S. Neuroendocrine carcinoma of the ampulla of Vater :a clinicopathogic evaluation. Hepatobiliary Pancreat Dis Int 2008;7:422-425.PIMD :18693180
2. Mavroudis N, Rafailadis S, Syemeonidis N, Aimoniotou E, Antonopoulos E, Evgenidis N etal Carcinoid of Ampulla of vater – a report of two cases.Act Chir Belg 2005;105:213-216.
3. Albores- Saavedra J, Hart A, Chable- Montero F, Henson DE. Carcinoid and high grade Neuroendocrine Carcinoma of the Ampulla of Vater- A camparitive analysis of 139 caese from Surveillance , Epidemiology , and End Results Program- A population based Study.Arch Pathol Lab Med 2010;134:1692-1696.PIMD:21043824
4. Jaoude WA,Lau C, Sugiyama G, Duncan A. Management of Ampullary Carcinoid tumor with Pancreaticoduodenectomy.JSCR 2010;8:4.
5. Beasley MB, Thunnissen FB, Hasleton P .Carcinoid tumor. In Travis WD, Brambilla E, Muller –Hermelink KH, Harris CC. Pathology and Genetics of Tumors of the lung , Thymus , Heart . Lyon, France :IARC Press; 2004:59-62.World Health Organisation Classification of Tumors ; vol 10.
6. Klimstra D, Modlin IR, Coppola D, Loyd R, Suster S. The pathologic classification of neuroendocrine tumors, A review of nomenclature, grading and staging systems. Pancreas 2010;39:707-12.
7. BosmanF,Carneiro F,Hruban R,Theise N, eds.WHO Classificationof Tumors of The Digestive System.Lyon, France:IARC Press;2010.
8. RindiG, Kloppel G,Couvelard A.TNM staging of midgut and hindgut (neuro)endocrine tumors :a consensus proposal including a grading system.Virchow Arch.2007;451:757-62.
9. Hartel M, Wente MN, Sido Bernd, Friess H, Buchler MW. Carcinoid of the ampulla of vater. Journal of Gastroenterology and Hepatology 2005;20:676-681.
10. Carter JT, Grenert JP, Rubenstein L, Stewart L, Way LW. Neuroendocine tumors of the Ampulla of vater. Biological behaviour and surgical management. Arch Surg 2009;144:527-531.PIMD:19528385
11. Klein A, Clemens J, Cameron J. Periampullary neoplasms in von Recklinghausen disease. Surgery 1989;106:815-9.
12. Relles D, Back J, Witkiewicz A, Yeo CJ. Periampullary and Duodenal neoplasms in neurofibromatosis type I :two cases an updated 20-year review of the literature yielding 76 cases. J Gastrointest Surg 2010;14:1052-61.PIMD:20300877
13. Gilani N, Ramirez FC. Endoscopic resection of an ampullary carcinoid presenting with upper gastrointestinal bleeding : A case report and review of literature.World J Gastroenterol 2007;13:168-70.PIMD:17451212
14. Senda E, Fujimoto K, Ohnishi K, Higashida A, Ashida C, Okutani T etal. Minute ampullary carcinoid tumor with lymph node metastasis : a case report and review of literature. World Journal Of Surgical Oncology2009;7:9. PIMD :19159493
15. Singhal D, Vasdev N, Soin A, Gupta S, Nundy S. Distinguishing between periampullary carcinoid and carcinomas: is this possible preoperatively.Indian J Gastroenterol 2006;25:206-7.PIMD:18693180
16. Karatzas G,Kouraklis G,Karayiannakis A,Patapis P,Givalos N,Kaperonis E. Ampullary and jejunal stromal tumor associated with Vion Recklinghausen’s disease presenting as gastrointestinal bleeding and jaundice. Eur J Surg Oncol 200;26:428-429.
17. Hatzitheoklitos E, Büchler MW, Friess H, Poch B, Ebert M, Mohr W etal. Carcinoid of the ampulla of vater , clinical characterstics and morphological features. Cancer1994 ;73:1580-1588.
18. Makhlouf HR, Burke AP, Sobin LH.Carcinoid of the ampulla of vater : a comparison with duodenal carcinoid tumors .Cancer 1999;85;1241-1249.
19. Norton JA, Kivlen M , Li M, Scheider D, Chuter T, Jensen RT. Morbidity and mortality of aggressive resection in patients with advanced neuroendocrine tumors. Arch Surg 2003;138;859- 866.
20. Poultides GA,Frederick WA. Carconoid of the ampulla of vater : Morphologic features and clinical implications. World J Gastroenterol.2006;12:7058-60.PIMD:17109507
21. Hwang S, Lee SG, Lee YJ, Han DJ, Kim SC, Kwon SH etal. Radical surgical resection for carcinoid tumors of the ampulla. J Gastrointest Surg 2008;12:713-7.
22. Pyun DK, Moon G, Han J, Kim MH, Lee SS, Seo DW.A carcinoid tumor of the ampulla of vater treated by endoscopic snare papillectomy. The Korean Journal of Internal Medicine 2004;19;257-260.
23. Sakka N, Smith RA, Whelan P, Ghaneh P, Sutton R, Raraty M etal. A preoperative score for resected pancreatic and periampullary neuroendocrine tumors.Pancreatology 2009;9;670- 676.PIMD:19684431
24. Jarufe NP, Coldham C, Orug T, Mayer AD, Mirza DF, Buckels JA etal. Neuroendocrine tumors of the pancreas: predictors of survival after surgical treatment. Dig Surg 2005; 22:157-162.
25. Hochwald SN, Zee S, Conlon KC, Colleoni R, Louie O, Brennan MF etal. Prognostic factors in pancreatic endocrine neoplasms: an analysis of 136 cases with a proposal for low-grade and intermediate grade groups. J Clin Oncol 2002; 20:2633-2642.